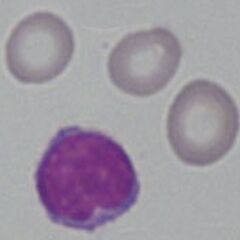
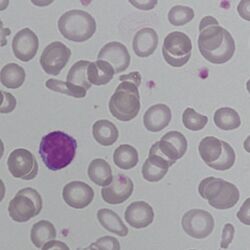

Microcytic and Hypochromic Red Cells
From haematologyetc.co.uk
Derivation: From the Greek hypo [under} and New Latin chromia [state of pigmentation]
Appearance
A cell containing insufficient haemoglobin – best detected as an increase when the area of pallor iof the erythrocyte extends beyond one third of the red cell diameter. The appearance tends to be obvious when the pallor exceeds half the cell diameter. In most circumstances hypochromic cells will also have reduced size (microcytosis).
Images The area of pallor in the center of the cell extends almost to the edge of the cell. The hypochromia indicates a reduced hemoglobin content. Hypochromatic cells are also generally small in size (microcytic). Note the small size (compare with the nucleus of the small lymphocyte).
Significance
The presence of hypochromia indicates defective production of haemoglobin. Most cases result from iron deficiency or thalassaemia – other typical features of these conditions should therefore be sought. Less frequently, hypochromia reflects defective iron utilisation (e.g. chronic disease or sideroblastic anaemia). The presence of hypochromia is not of itself an urgent problem unless there is severe anaemia; however, it important to highlight the condition since clinicians may need to request further investigation to determine its cause.
Pitfalls
Be sure you are viewing the correct area of the film – the central pallor is clearly shown only in the area where red cells first begin to contact each other. Poorly stained films may also be a problem – remember it is the extent of the area of pallor that is important not the stain colour. Finally, central pallor probably cannot be accurately assessed in damaged or abnormally shaped cells unless the hypochromia is very severe.
| DEFECTIVE IRON AVAILABILITY OR USAGE |
|---|
| Iron deficiency |
| Anaemia of chronic disease |
| Less commonly: Sideroblastic anaemia, Heavy metal poisoning |
| DISORDERS OF HAEMOGLOBIN |
| Thalassaemia syndromes: are the principle inherited cause of hypochromia (look for associated features) |
| Other haemoglobinopathies: tend not to be hypochromic unless there is associated thalassaemia or iron deficiency. There may be a mild microcytosis. |
Clinical Image 1: Hypochromic microcytic red cells Note the small size in comparison to the nucleus of the small erythrocyte. The erythrocytes are variable in size (anisocytosis); however, the major feature is the hypochromia the area of central pallor extends to around 60-70% of the cell diameter. Clinical condition: iron deficiency
Clinical Image 2: Hypochromic microcytic red cells In this case the overall staining and background is more grey in shade; however the appearance is otherwise identical to the previous example. Two elongated pencil cells are also shown. Clinical condition: iron deficiency
Clinical Image 3: Hypochromic microcytic red cells Note the variability in size although in most cases this is clearly reduced compared with the nucleus of the lymphocyte the hypochromia is much more difficult to detect as many of the cells are target cells; however, the rim of haemoglobin is very narrow. There is a single polychromatic cell and the edge of a nucleated red cell can be seen. Clinical condition: thalassaemia intermedia
Pathobiology
The biconcave disk shape of erythrocytes means that when flattened on a glass slide the central area of the cell appears pale; when the haemoglobin content of a red cell is reduced this pale area becomes more extensive. Reduced cellular haemoglobin generally arises either from reduced haem formation (particularly iron deficiency) or from reduced globin chain synthesis (thalassaemia).